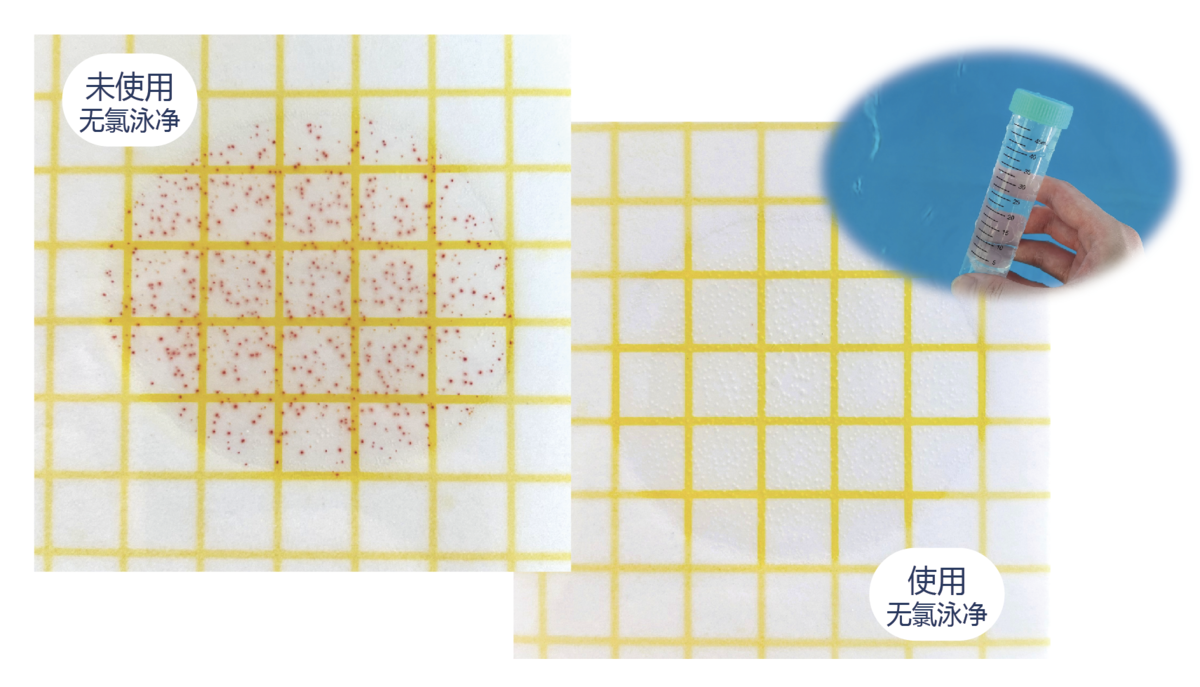

无氯泳净
泳池专用
无氯消毒配方,温和不刺激。采用AB试剂联合使用,A试剂构建长效消毒体系,B试剂释放消毒因子,立体杀灭水中有害菌和藻类。
温和不刺激
采用低刺激配方,正常使用下水质清澈无异味,不造成皮肤和眼部刺激。

低用量,快灭菌,更经济
使用无氯泳净后水中细菌数量远远优于标准要求,水质清澈无异味。对比传统含氯消毒剂无氯泳净用量更少价格更实惠。
*实验数据来自颐科实验室和场地测试
应用场景


使用颐科无氯泳净后水体产生沉淀量减少,水质清澈不刺激皮肤。
联系我们
电话:
+86 13128844724 +852 67353157
邮箱:
ecotech-service@
颐科环保科技 EcoTech
颐科环保科技(EcoTech)成立于2023年是专注于水产养殖水质处理领域的初创企业。智能水凝胶系列产品,通过缓释技术实现一次投药长效维持水质健康。颐科以水体可持续治理探索者,标准化水产养殖领路者作为发展目标。
https://user-assets.sxlcdn.com/images/1179781/Fm2UEyQ8gLerU_l6ud9DjaC7y9eM.png?imageMogr2/strip/auto-orient/thumbnail/1200x630>/quality/90!/format/png
粤公网安备44030002004269号